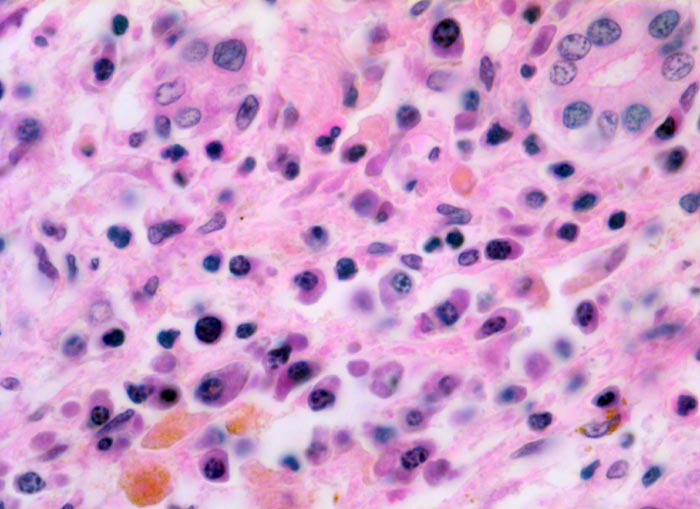

PathoPic – image database / PathoPic ID 5140 - akute Hepatitis
de
Diagnose
akute Hepatitis
Diagnose Gruppe
Entzündung infektiös
Topographie
Leber
Topographie Gruppe
Leber, Gallenwege, Pankreas
Beschreibung
Klinik
Autopsiepräparat eines 37jährigen Patienten mit Transaminasenanstieg und Hyperbilirubinämie. St.n. Bluttransfusionen
Kommentar
Die hämosiderinbeladenen Kupfferschen Sternzellen sind als Transfusionssiderose zu deuten. Zeroid ist ein schmutzig braun schwarzes Pigment. Goldgelb glänzende intrazelluläre Körnchen entsprechen dagegen Hämosiderin.
Bilder Typ
Histologie
Vergrösserung
630
Alter
37
Geschlecht
männlich
Datum
Ersteintrag: 21.10.2002